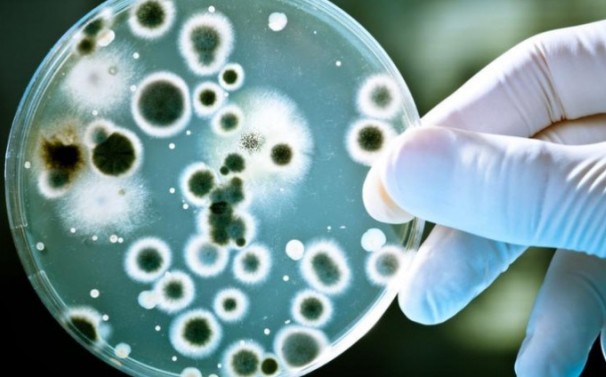

Najčešći uzročnici spolno-prenosivih bolesti su klamidija i mikoplazma, bakterije koje se prenose spolnim kontaktom.
Infekcije izazvane ovim bakterijama lako se liječe antibioticima, dok neliječene infekcije mogu ostaviti teške posljedice, koje uključuju i nepovratno oštećenje reproduktivnih organa u oba spola, što može za posljedicu imati neplodnost (nemogućnost začeća – sterilitet), ali i ektopičnu trudnoću (opasnu trudnoću po život trudnice, nastalu izvan maternice).
Čak jedna od 16 spolno aktivnih mladih osoba od 18 do 25 godina ima spolno prenosivu infekciju izazvanu klamidijom. Znakovi i simptomi te infekcije znaju biti dosta nejasni ili izostaju, često kod djevojaka, pa je važno da se testirate ako ste mlađi od 25 godina, naglašavaju na stranicama Nastavnog zavoda za javno zdravstvo “Dr. Andrija Štampar”.
Osim toga, utječe i na prerano rođenje djeteta koje može izazvati zdravstvene poteškoće te biti opasno i za majku i za dijete jer se bakterije na dijete mogu proširiti i tokom porođaja te dovesti do infekcije oka i pluća novorođenčeta.
Većina zaraženih ljudi ni ne osjeća se i izgleda posve zdravo, a možda ni ne znaju da su zaraženi i da infekciju mogu prenositi drugima. Zato vodite brigu o vašem spolnom zdravlju i zaštitite se od neželjenih komplikacija u budućnosti.
Uzorkovanje je vrlo jednostavno i bezbolno. Uzimate ga sami, a za prikupljanje pogodnih uzoraka nije potrebna posjeta liječniku. Pogodan uzorak u oba spola je prvi mlaz (prvih 20 ml) mokraće prikupljene u sterilnu posudicu za mokraću najmanje dva sata od zadnjeg mokrenja, a u mladih djevojaka, odnosno žena pogodan uzorak je i obrisak rodnice koje mogu učiniti same.
Ako je test pozitivan, nema razloga za paniku. Infekcija se uspješno liječi antibioticima. Jedino je važno da uzimate antibiotike onako kako je liječnik propisao i da ne prekidate propisanu terapiju.
Važno je zapamtiti i da se vaš partner također mora liječiti. Rizik zaraze spolno prenosivim bolestima možete smanjiti tako da upotrebljavate kondom svaki put kad imate spolni odnos (da, čak i oralni).
Posljedice su širenje upale i neplodnost
Moguće posljedice klamidijske infekcije su širenje upale na zdjelične organe, maternicu, jajovode, jajnike i okolno tkivo s mogućim ozbiljnim i trajnim posljedicama na opće i reproduktivno zdravlje sve do izvanmaternične trudnoće ili neplodnosti. Liječenje je važno započeti što ranije i liječiti oba partnera.
Simptomi mogu, ali i ne moraju biti izraženi
Uzročnik klamidijske infekcije je bakterija Chlamydia trachomatis. To je najproširenija spolno prenosiva infekcija, naročito u adolescenata. Kod djevojaka se simptomi ne javljaju često, moguć je svrbež oko spolovila ili anusa, peckanje pri mokrenju, promijenjen ili pojačan iscjedak, nelagoda u donjem trbuhu ili krvarenje iz rodnice izvan menstruacije.
Kod mladića najčešće nema simptoma, iako i oni mogu osjetiti lagano peckanje pri mokrenju, iscjedak iz spolovila, pečenje ili svrbež oko spolovila, nelagodu te bol u testisima.
Svi rizični faktori spolno prenosivih bolesti
Dob stupanja u spolne odnose – naročito je podložan osjetljiv mlad organizam
Spol – djevojke su osjetljivije od mladića
Broj partnera – više partnera i partneri s rizičnim ponašanjem
Spolni odnos bez zaštite – nekorištenje kondoma
Spolni odnos pod utjecajem alkohola
Postojanje ranije prenosive infekcije